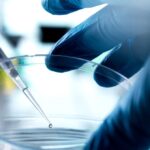

Melhor que elétrico, mas o Sixpack terá odiadores
No início deste ano, Stellantis confirmou que o Dodge Charger Sixpack chegaria neste verão. Bem, o verão está chegando, e Dodge está se preparando para manter sua palavra. Nesta semana, um usuário do Reddit estava à margem de uma sessão que, sem dúvida, fará parte de um novo anúncio comercial, e seu curto videoclipe revela o som turbo do furacão, seis em um carregador vermelho, pois o cupê é brevemente deslizado em torno de um canto para uma foto do drone.
Embora o Sixpack certamente pareça muito melhor do que os ruídos sintetizados de Daytona totalmente elétricos, isso não vai agradar a todos. Alguns compararam o som ao dos motores turbo alemães, enquanto outros simplesmente o chamaram de “desagradável”. Ouça por si mesmo e deixe -nos saber o que você pensa.
Mais por vir em breve
Há pouco tempo, a demanda fraca forçou a Dodge a, pelo menos temporariamente, Puxe o plugue do carregador de 496 cavalos de potência Daytona R/T (A versão básica do Muscle EV), por isso esperamos que o Sixpack chegue aos revendedores em breve para ajudar a pegar a folga. Isso será enviado com o motor de 420 hp de saída padrão. Depois disso, a Espera -se que a Outlaw Sixpack Para elevar a barra com o motor de furacão de alta saída e, se os relatórios forem precisos, isso fornecerá sua respeitável 550 cavalos de potência e 521 lb-ft de torque para todas as quatro rodas, com um modo de tração traseira selecionável para tornar as coisas mais emocionantes no giro de um interruptor. Twin-Turbo Straight-Six, mais de 500 pôneis e a capacidade de derreter os pneus traseiros? Isso está se transformando em ser um americano M4 com um preço muito menos aterrorizante.
Relacionado: 2026 BMW M3 O preço é tão assustador quanto desligar a tração
Não desista do sonho V8 ainda
Simplesmente Voltando à combustão Pode não ser suficiente para tornar o Dodge Charger popular novamente, e Dodge sabe disso. Com nova liderança no comando Stellantis, Os motores V8 podem muito bem retornar ao carregadore olhando para o influxo notável de ordens que Ram recebeu Uma vez que reviveu a opção de um V8, certamente é apenas uma questão de tempo até que o carregador possa realmente rivalizar Mustang gt com um grande oito cilindros novamente.
Dito isto, mesmo o Mustang não é tão popular quanto antese Stellantis precisa pisar com cuidado. Há uma razão pela qual É improvável que o Camaro se junte à luta de carros muscularescom relatórios recentes indicando que um sedan pode estar o mais próximo possível; Hoje em dia, os compradores estão mais felizes em gastar em crossovers do que em cupês.